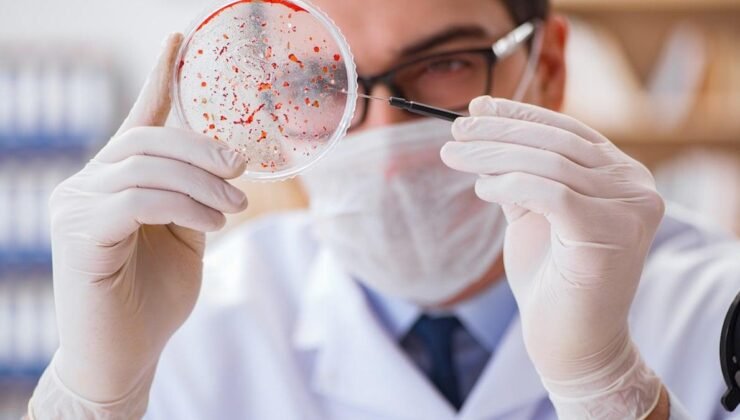
CAR-NK Tedavisiyle Waldenström Makroglobulinemi’nde Yeni Umut: Tedaviye Yanıt Veren Hastalarda Tam İyileşme

ABD merkezli ImmunityBio tarafından yürütülen bir klinik çalışmada, NK hücrelerini kullanarak bağışıklık sisteminin doğal savunmasını kanserle mücadele için uyarmak hedeflendi. Çalışma, nadir görülen bir kan kanseri türü olan Waldenström Makroglobulinemisi (lenfoplazmasitik lenfoma) hastalarında kemoterapi ihtiyacını azaltmaya odaklandı ve bazı hastalarda olumlu sonuçlar elde edildi.

CD19 CAR-NK hücre terapi yöntemi ile Rituximab birleşiminin dört hasta üzerinde uygulandığı çalışmada, iki hastada hastalığın tamamen gerilediği kaydedildi. İzlem sonrası 7 ve 15 aylık takiplerde belirti ya da aktüel hastalık göstergesi görülmedi. Özellikle kemik iliğinin yaklaşık %95’inin tümörle dolu olduğu bir durumda bile yalnızca dört doz tedaviyle tam iyileşmenin sağlandığı bulgusu dikkat çekti.
TEDAVİYE YANIT veren dört hastanın tamamı, mevcut standart tedavilere karşı dirençli süreçlerden sonra bile hastalığın kontrol altına alınabildiğini gösterdi. Çalışmayı yöneten Dr. Patrick Soon-Shiong, bağışıklık sisteminin yeniden aktive edilmesiyle kanserin etkili bir şekilde baskılanabildiğini ifade etti. Hasta sayısı sınırlı olsa da, tedavi bittikten bir yıl sonra dahi iyileşmenin sürmesi bu yaklaşımı kayda değer kılıyor.
HASTANELERE YATIŞ GEREK DUYULMUYOR Yeni CAR-NK yaklaşımı, geleneksel CAR-T tedavilerinden bazı yönleriyle ayrılıyor. Hastanın kendi hücrelerinin laboratuvar ortamında uzun süre işlenmesi gerekliliği ortadan kalkabilir; bu sayede tedavi daha hızlı uygulanabiliyor. Ayrıca hastanın yatış gerektirmeden ayakta uygulanabilir olması ve şimdiye kadar kaydedilen ciddi yan etkinin olmaması dikkat çekiyor.
İPUCU VE GELECEK ADIMLAR Tedavinin temelinde, vücutta doğal olarak bulunan NK hücrelerinin genetik olarak modifiye edilmesi yer alıyor. Hücrelere CD19-CAR alıcısı ve bağışıklık sisteminin antikorlarla koordineli çalışmasını sağlayan CD16 alıcısı eklenerek kanserli hücreler daha hızlı hedefleniyor. Rituximab’ın eklenmesiyle bu etki güçleniyor. Bulguların Amerikan Hematoloji Derneği’nin yıllık toplantısında paylaşılması planlanıyor ve Waldenström makroglobulinemisinin genellikle iyileşmesi zor bir durum olduğu bilgisini vurguluyor. Şirket, olumlu sonuçları daha geniş hasta grubunda doğrulamak üzere çalışmalarını sürdürüyor.